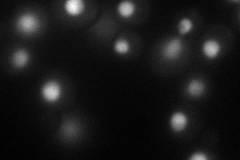
YML062C
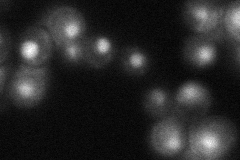
YML062C
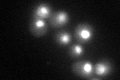
YML062C
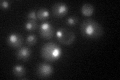
YML062C

View description
Subunit of the THO complex, which is a nuclear complex comprised of Hpr1p, Mft1p, Rlr1p, and Thp2p, that is involved in transcription elongation and mitotic recombination; involved in telomere maintenance
Localization:
Intensity:
Fold change:
Significance:
-
C’ GFP library in SD

nucleus38.15 -
N' NOP1pr-GFP in SD
nucleus83.4815 -
N' TEF2pr-mCherry in SD

nucleus100.687 -
N' NATIVEpr-GFP in SD
nucleus35.1872 -
N' TEF2pr-VC and Cyto-VN in SD

nucleus34.5477 -
C’ GFP library in SD+DTT
nucleus38.691.01No -
C’ GFP library in SD+H2O2

nucleus41.861.09No -
C’ GFP library in Starvation Media
nucleus56.951.49Yes -
C’ GFP library on the background of Pup2-DaMP

nucleus -
C’ GFP library on the background of CCT mutant

nucleus34.95690.916178No
